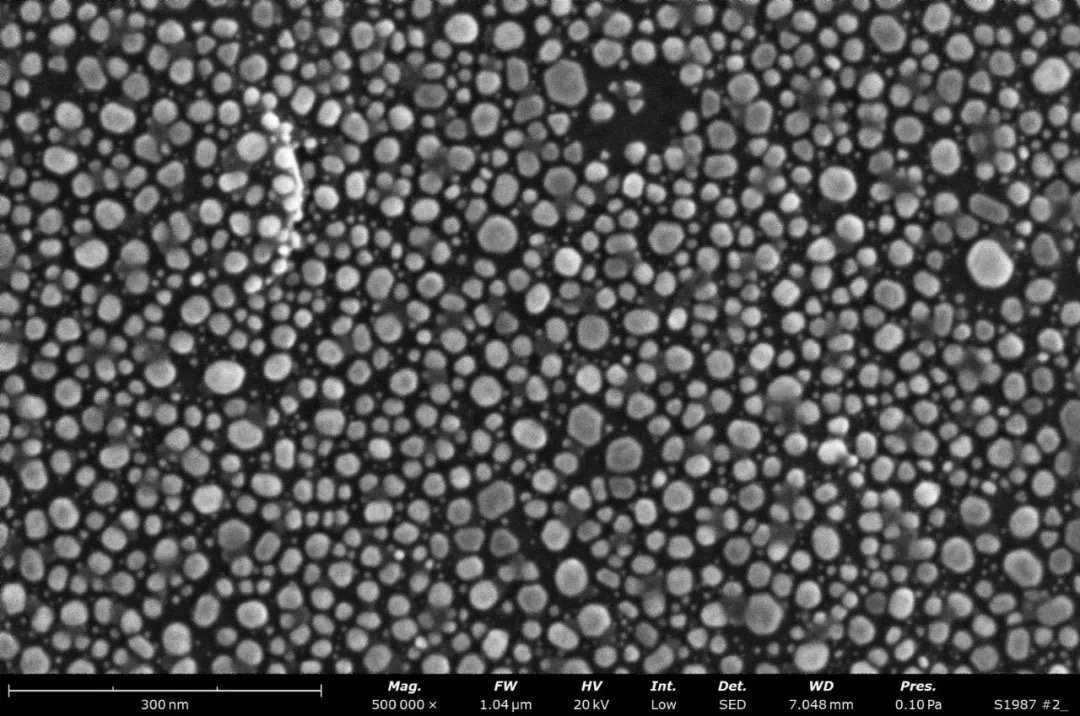

復(fù)納科學(xué)儀器(上海)有限公司
 金牌會(huì)員
金牌會(huì)員 已認(rèn)證
已認(rèn)證

復(fù)納科學(xué)儀器(上海)有限公司
 金牌會(huì)員
金牌會(huì)員 已認(rèn)證
已認(rèn)證
荷蘭飛納推出第二代肖特基場(chǎng)發(fā)射電子源臺(tái)式掃描電鏡 Phenom Pharos G2, 集背散射電子成像、二次電子成像和能譜分析功能于一體。高亮度肖特基場(chǎng)發(fā)射電子源,使用戶可以輕松獲得高分辨率圖像,且低電壓性能優(yōu)異。

第二代臺(tái)式場(chǎng)發(fā)射電鏡 Phenom Pharos G2 的分辨率提升至優(yōu)于 1.8 nm,廣泛用于半導(dǎo)體、生物學(xué)、醫(yī)學(xué)、金屬材料、高分子材料、化工原料、地質(zhì)礦物、商品檢驗(yàn)、產(chǎn)品生產(chǎn)質(zhì)量控制、寶石鑒定、考古和文物鑒定及公安刑偵物證分析。
分辨率優(yōu)于 1.8 nm
具有卓越的成像質(zhì)量,是目前分辨率最高的臺(tái)式掃描電鏡。優(yōu)于 1.8 nm 的分辨率,可以輕松獲取樣品的更多細(xì)節(jié)信息。
樣品:金顆粒 放大倍數(shù):50萬倍
加速電壓低至 1kV
新一代場(chǎng)發(fā)射系列低電壓性能優(yōu)異,加速電壓范圍向下調(diào)低至 1kV, 無需特殊制樣,無需擔(dān)心荷電,可減輕電子束對(duì)樣品的損傷和穿透,更好地觀測(cè)絕緣和電子束敏感的樣品,可以最大程度地還原樣品的真實(shí)形貌。


5 kV 充電嚴(yán)重 1 kV 充電消失
UI 界面全面升級(jí)
一切以圖像為中心,用戶界面全面升級(jí),取消傳統(tǒng)的能譜獨(dú)立顯示屏,將電鏡、能譜、全景拼圖等操作界面集成在 1 個(gè) 24 英寸顯示屏上,為用戶提供最佳的操作體驗(yàn)。無需切換即可使用實(shí)時(shí)能譜功能,在成像的同時(shí),快速獲取成分信息。

基本參數(shù)
· 燈絲材料:肖特基場(chǎng)發(fā)射燈絲
· 分辨率 :優(yōu)于 1.8nm
· 電子放大:最大 200 萬倍
· 加速電壓:1kV-20kV, 連續(xù)可調(diào)
· 內(nèi)置 UPS(不間斷電源)適配器
· 全面升級(jí)為新 UI:電鏡、能譜等在同一界面
最新動(dòng)態(tài)
更多





虛擬號(hào)將在 秒后失效
使用微信掃碼撥號(hào)